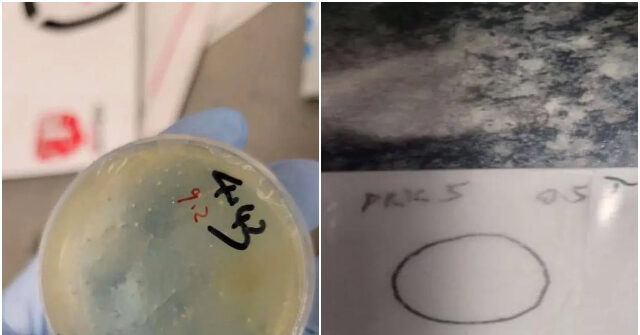
Chinese Individual Arrested and Accused of Smuggling Biological Materials

GovPlanet will return border wall materials to the federal government.

Government Auction House Plans to Return Border Wall Materials In a recent update, a global auction house, which specializes in selling unused materials from President Donald Trump’s border wall under the Biden administration, announced plans to collaborate with the Trump administration to return some of these materials to the federal government. Since President Joe Biden’s […]
Reasons Behind the Rise of MP Materials Stock This Week

Sales losses from Chinese customers have been offset by a boost in rare earth material sales. The company is gearing up to collaborate with the Department of Defense, which has led to increased sales of its rare earth magnets. Rare Earth Materials and Magnet Company stocks, specifically MP Materials, might see an increase of 11.6% […]
China holds 80% of essential battery materials required for US defense technology

China’s Dominance in Battery Materials Threatens National Security A recent report suggests that China now controls over 80% of the essential raw materials necessary for battery production, which is crucial for defense technologies. This presents a significant national security concern. Challenges in the permitting process at LAX, along with weak environmental regulations and strong government […]
These 3 Rare Earth Stocks Are Rising with MP Materials

Surge in Rare Earth Mineral Stocks This July July has been a noteworthy month for rare earth mineral stocks, with MP Materials taking the lead. On July 10th, shares of MP soared nearly 51% following an announcement regarding substantial commitments from the Department of Defense to support U.S. rare earth magnet independence. A few days […]
Apple signs $500 million agreement with US rare-earth mine operator MP Materials

Apple’s $500 Million Contract for Rare Earth Materials Apple has entered into a significant $500 million agreement with operators of mines in Texas, aimed at sourcing materials for iPhones and other devices. This initiative reflects the company’s strategy to lessen its reliance on China. Based in Cupertino, California, Apple is setting up a multi-year partnership […]
Woman accused in Texas ICE attack encouraged husband to conceal ‘anti-Trump’ materials: sources

A member of the armed group that allegedly ambushed immigration and customs enforcement agents at a Texas detention center on July 4 is reportedly concealing her immigrant husband in an effort to hide evidence from authorities. Sources revealed that Marisela Ruda is believed to be keeping her husband, Daniel Rolando Sanchez Estrada, out of prison, […]
Trump refutes claims that Iranians relocated nuclear materials prior to US strikes

On Wednesday, President Trump asserted that no nuclear material had been moved from an Iranian facility, despite earlier internal assessments indicating otherwise before a recent strike. “We’re the exact opposite. We hit them hard and fast. They couldn’t move anything,” Trump stated during a press conference at the NATO summit, responding to questions about whether […]
IAEA leader states Iran possesses materials for warheads but lacks a weapon program.

Update on Iran’s Nuclear Capabilities Recently, President Donald Trump has expressed support for Israel’s efforts to neutralize Iran’s nuclear capabilities. However, nuclear officials from various nations have indicated to Fox News that they see no current signs that Iranian leaders are actively pursuing the development of a nuclear bomb. “We’ve confirmed that Iran retains sufficient […]
Chinese Individual Arrested and Accused of Smuggling Biological Materials
A Chinese national has been arrested, facing allegations of smuggling biological materials into the U.S. and making false statements, as reported by the U.S. attorney’s office in eastern Michigan. U.S. attorney Jerome F. Gorgon Jr. announced the arrest of Chengxuan Han, a citizen of China. According to the complaints, Han is a citizen of the […]
Chinese citizen detained for trafficking biological materials from Wuhan

A Chinese national, Chengxuan Han, was arrested for allegedly smuggling biological materials into the United States and providing false information to Customs and Border Protection (CBP) officials regarding her package contents. The Justice Department has charged Han with these offenses. According to legal documents, Han is a doctoral student from Huatu Hong University of Science […]









